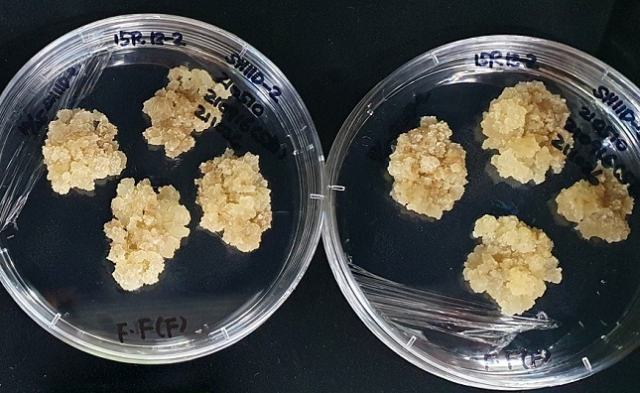
실제 장미와 똑같은 향 성분을 가진 세포 배양체. 농촌진흥청 제공

농촌진흥청, 실제 장미 향과 똑같은 세포배양체 기술개발
- 가
바이오에프디엔씨와 공동연구
향기보존 배양 성공 세계 처음
화장품 원료로 만들어 판매 계획
실제 장미와 똑같은 향 성분을 가진 세포 배양체. 농촌진흥청 제공
실제 장미와 똑같은 향 성분을 가진 세포 배양체. 농촌진흥청 제공
세계 최초로 실제 장미와 똑같은 향 성분을 가진 세포 배양체를 만들어냈다.
농촌진흥청은 “실제 장미 꽃잎과 똑같은 향기 성분을 보유한 식물 세포 배양체(캘러스)를 유도하는 데 성공했다”고 3일 밝혔다.
‘식물의 줄기세포’로도 불리는 식물 세포 배양체는 식물에 상처가 났을 때 상처 부위에 생겨나는 조직이다. 생리활성물질을 고농도로 함유하고 있다.
식물을 화장품 소재 등으로 활용할 때 세포 배양체를 이용하면 재배 과정에서 환경 영향을 최소화해 좋은 성분을 대량으로 증식할 수 있다.
우리나라 화장품 시장은 원료의 80% 이상을 수입에 의존하고 있어 경쟁력 강화를 위해서는 원료의 국산화가 시급하다. 또 최근 식물 세포 배양체에 대한 수요가 늘고 있어 기술 개발이 절실한 상황이다.
이에 농촌진흥청은 자원 출처가 명확하고 향기가 우수한 우리나라 장미 품종을 활용해 화장품 소재화 기술 개발 연구에 착수했다. 연구는 세포 배양 추출물을 식의약품·화장품 소재로 개발해 판매하는 ㈜바이오에프디엔씨와 공동으로 진행했다.
연구진은 먼저, 차아염소산소다(NaOCl) 0.5% 용액에 꽃잎을 소독한 뒤 생장조절 물질을 첨가하고 영양체(배지)에 꽃잎 표면을 배지에 맞닿게 하는 방식으로 세포 배양체 유도 조건을 만들었다.
이 조건에 맞춰 상큼한 향을 지닌 우리 장미 ‘15R12-2’ 계통의 세포 배양체를 유도했다. 그 결과, 세포 배양체는 실제 꽃과 동일한 향기 성분을 최대 59%가량 보유하고 있었으며, 관련 유전자 4종도 안정적으로 발현됐다.
세계적으로 장미 세포 배양체 연구가 이뤄지고 있지만, 실제 꽃잎과 동일한 향기까지 온전히 보존하면서 세포 배양에 성공한 것은 이번이 처음이다. 이번 성과는 2023년 국제 학술지 ‘플랜츠(Plants)’에 실려 학술적으로 인정받았다.
국립원예특작과학원은 세포 배양체 12종을 증식한 뒤 생물자원으로 활용토록 한국생명공학연구원에 기탁했다. 또 피부보호 효능·효과 분석을 마친 꽃잎 세포 배양체 2종을 ㈜바이오에프디엔씨와 함께 화장품 소재로 특허출원했다.
바이오에프디엔씨 관계자는 “우리나라 장미 품종(계통) 꽃잎의 세포 배양체를 대량 증식한 뒤 여기서 나온 화장품 원료 추출물을 반제품이나 완제품으로 만들어 판매할 계획”이라고 전했다.
농촌진흥청 국립원예특작과학원 화훼과 이영란 과장은 “앞으로 장미뿐만 아니라, 국화 등으로 세포 배양체 유도와 산업 소재화 연구를 확대해 우리 화훼산업의 영역을 확장해 가겠다”라고 말했다.
김덕준 기자 casiopea@busan.com
당신을 위한 AI 추천 기사
실시간 핫뉴스















